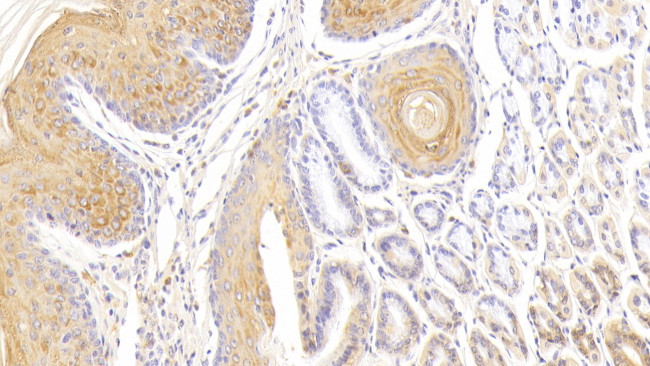
cGAS Antibody in Immunohistochemistry (Paraffin) (IHC (P))

Search
Invitrogen
cGAS Polyclonal Antibody
{{$productOrderCtrl.translations['antibody.pdp.commerceCard.promotion.promotions']}}
{{$productOrderCtrl.translations['antibody.pdp.commerceCard.promotion.viewpromo']}}
{{$productOrderCtrl.translations['antibody.pdp.commerceCard.promotion.promocode']}}: {{promo.promoCode}} {{promo.promoTitle}} {{promo.promoDescription}}. {{$productOrderCtrl.translations['antibody.pdp.commerceCard.promotion.learnmore']}}
图: 1 / 2
cGAS Antibody (PA5-122176) in IHC (P)


Please note: We are reviewing Western blot images included in the antibody testing data in our catalog, including those provided by third parties. Unless expressly labeled or annotated as “raw-unedited”, Western blot images included in the antibody testing data in our catalog may have been edited, optimized or otherwise adjusted for presentation.
产品信息
PA5-122176
种属反应
宿主/亚型
分类
类型
抗原
偶联物
形式
浓度
规格
纯化类型
保存液
内含物
保存条件
运输条件
RRID
靶标信息
cGAS (Cyclic GMP-AMP synthase) is a nucleotidyltransferase that catalyzes the formation of cyclic GMP-AMP (cGAMP) from ATP and GTP and plays a key role in innate immunity. Catalysis involves both the formation of 2', 5' phosphodiester linkage at the GpA step and the formation of 3', 5' phosphodiester linkage at the ApG step. This produces c[G(2',5')pA(3'5')p] responses. cGAS also binds cytosolic DNA directly, leading to the activation and synthesis of cGAMP. Then, a second messenger binds to and activates TMEM173/STING thereby triggering type-I interferon production. cGAS is also involved in innate immune sensorship of infection, detection of DNA from bacteria, response to cellular stress, DNA damage, and regulation of cellular senescence.
仅用于科研。不用于诊断过程。未经明确授权不得转售。
篇参考文献 (0)
生物信息学
蛋白别名: 2'3'-cGAMP synthase; C6orf150; cGAMP synthase; Cyclic GMP-AMP synthase; h-cGAS; Mab-21 domain-containing protein 1; MB21D1
基因别名: C6orf150; CGAS; MB21D1
Entrez Gene ID: (Human) 115004